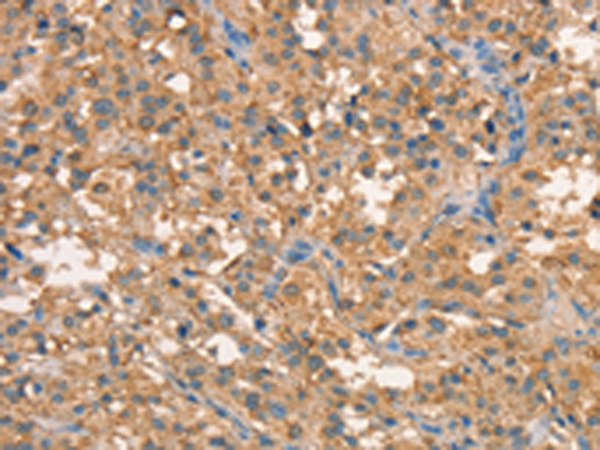
一抗

中文名稱:兔抗CRELD1多克隆抗體
|
Background: |
This gene encodes a member of a subfamily of epidermal growth factor-related proteins. The encoded protein is characterized by a cysteine-rich with epidermal growth factor-like domain. This protein may function as a cell adhesion molecule. Mutations in this gene are the cause of atrioventricular septal defect. Alternate splicing results in multiple transcript variants. |
|
Applications: |
ELISA, IHC |
|
Name of antibody: |
CRELD1 |
|
Immunogen: |
Synthetic peptide of human CRELD1 |
|
Full name: |
cysteine-rich with EGF-like domains 1 |
|
Synonyms: |
AVSD2; CIRRIN |
|
SwissProt: |
Q96HD1 |
|
ELISA Recommended dilution: |
2000-5000 |
|
IHC positive control: |
Human thyroid cancer and Human brain |
|
IHC Recommend dilution: |
50-200 |

 購物車
購物車 幫助
幫助
 021-54845833/15800441009
021-54845833/15800441009